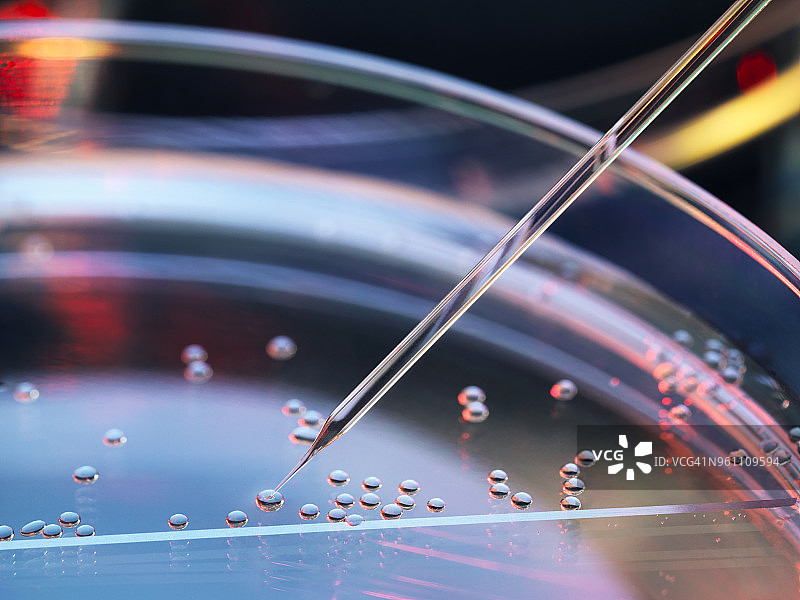

图片
- 图片
- 视频
- 音频
- 字体
干细胞研究:在多个胚胎干细胞上进行核移植克隆
干细胞研究:在多个胚胎干细胞上进行核移植克隆图片素材作品是由视觉中国旗下网站(VCG.COM)的图片品牌合作方:Westend61提供,作品作者是:Westend61/视觉中国;图片ID:VCG41N961109594;最大规格:5500 x 4125 px (300ppi) | TIFF 64.91 MB;存储大小:12.55 MB - JPG;授权方式是:;当前图片素材提供下载与正版授权服务,助力您的品牌提升。
图片ID:VCG41N961109594
作者/来源: Westend61/Getty Creative
品牌:Westend61
最大尺寸:5500 x 4125 px (300ppi) | TIFF 64.91 MB | 46.57 x 34.92 cm (18.33 x 13.75 in.)
存储大小:12.55 MB - JPG
购买咨询
